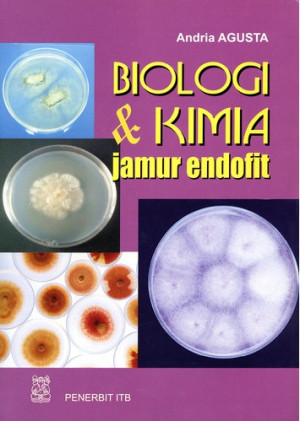
Image of Biologi dan Kimia Jamur Endofit

Cek Ketersediaan
Biologi dan Kimia Jamur Endofit
Tidak Tersedia Deskripsi
- Judul Seri
-
-
- No. Panggil
-
579.5 And b
- Penerbit
- Bandung : Penerbit ITB., 2009
- Deskripsi Fisik
-
7a, 110 hlm: ilustrasi; 25 cm
- Bahasa
-
Indonesia
- ISBN/ISSN
-
978-979-1344-42-5
- Klasifikasi
-
579.5
- Tipe Isi
-
-
- Tipe Media
-
-
- Tipe Pembawa
-
-
- Edisi
-
-
- Subjek
- Info Detail Spesifik
-
-
- GMD
-
Teks (Text)
- Pernyataan Tanggungjawab
-
-
Tidak tersedia versi lain
Tidak Ada Data